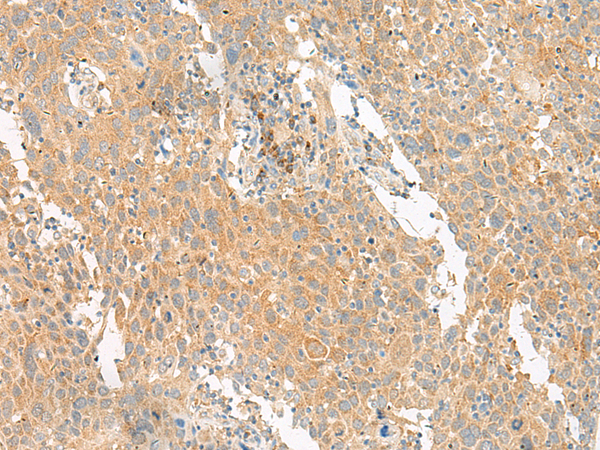

-
分类: 科研抗体货号: P13474别名: MEA-2; GCP170应用: WB,IHC反应种属: Human
-
分类: 科研抗体货号: P13453别名: GCET1; SERPINA11; SERPINA11b应用: WB,IHC反应种属: Human
-
分类: 科研抗体货号: P13472别名: GBT1; GNATR; CSNB1G; CSNBAD3应用: WB,IHC反应种属: Human, Mouse
-
分类: 科研抗体货号: P13452别名: REN53; GCC185; RANBP2L4应用: IHC反应种属: Human, Mouse, Rat
-
分类: 科研抗体货号: P13470别名: GLYT1; GCENSG应用: IHC反应种属: Human, Mouse, Rat
-
分类: 科研抗体货号: P13480别名: G2A应用: IHC反应种属: Human
-
分类: 科研抗体货号: P13467别名: GLUT8; GLUTX1应用: WB反应种属: Human, Mouse, Rat
-
分类: 科研抗体货号: P13479别名: C5L2; GPF77; GPR77应用: IHC反应种属: Human
-
分类: 科研抗体货号: P13466别名: GLTSCR1应用: IHC反应种属: Human
-
分类: 科研抗体货号: P13465别名: GA; GLS; LGA; hLGA应用: WB,IHC反应种属: Human, Mouse, Rat

鄂公网安备42018502007531号
鄂公网安备42018502007531号

